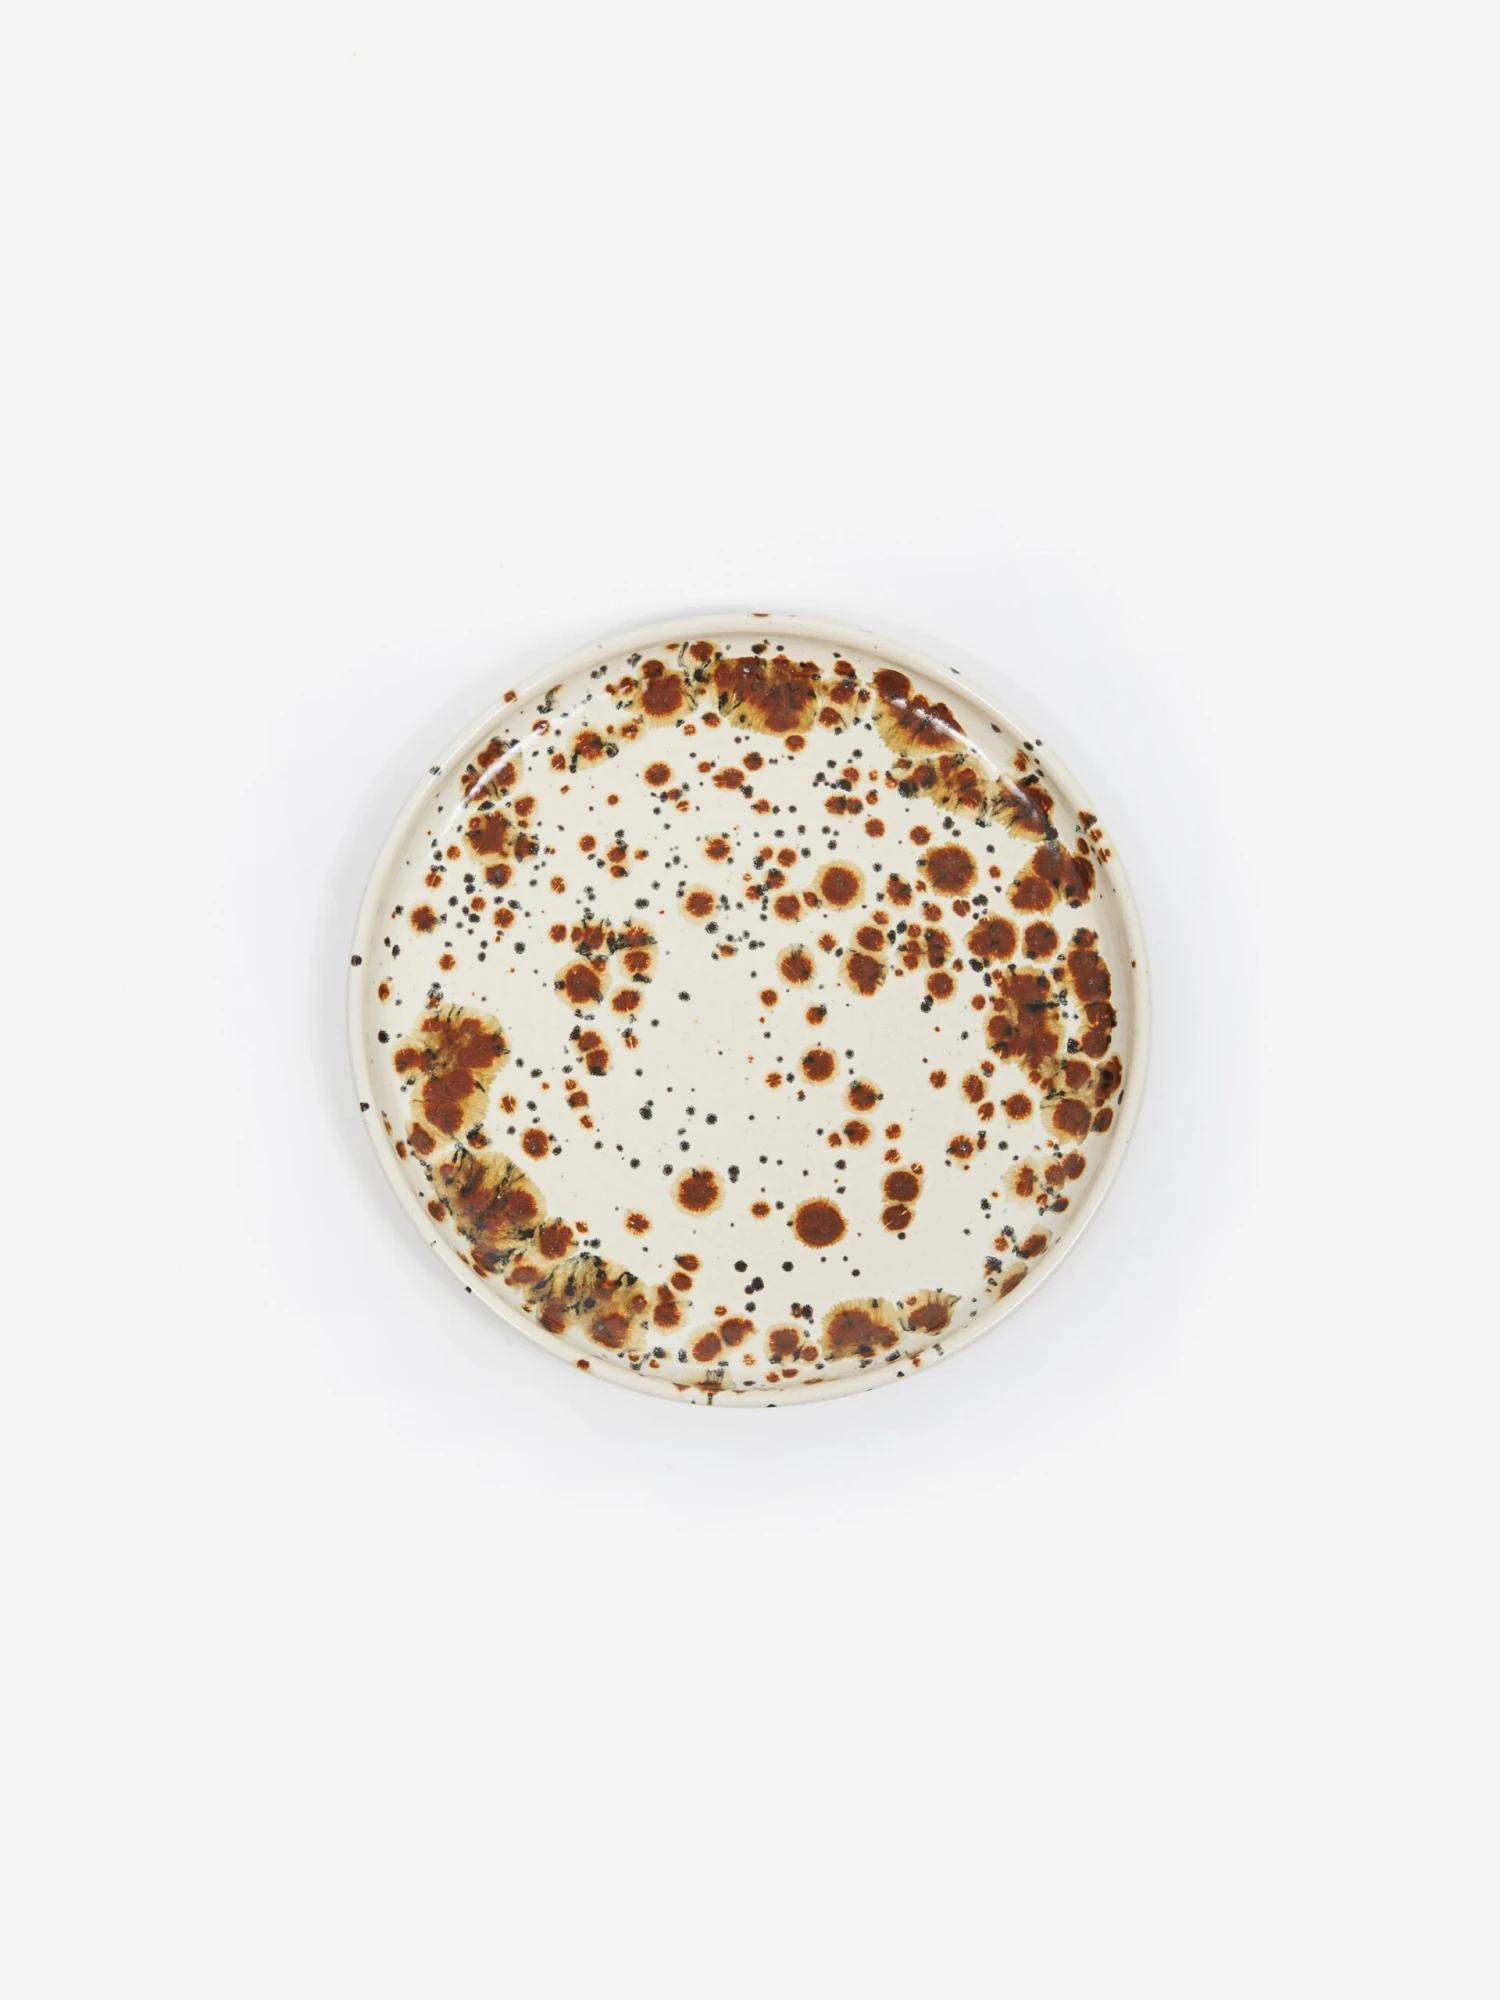
Liam Owen X Goodhood Freckle Handmade Dinner Plate - Freckle Glaze 5 Liam Owen X Goodhood Freckle Handmade Dinner Plate - Freckle Glaze - Image 3

Returning for a second season, we have teamed up with London-based maker Liam Owen for another exclusive collaboration. This earthy inspired glaze is exclusive to Goodhood. Having studied at the renowned Glasgow School of Art and graduating in 1997, Liam’s focus is ‘satisfyingly simple stoneware’ and he’s become known for his signature two-tone speckled glazes. This earthy inspired glaze is exclusive to Goodhood.
- Handmade in London
- Size: Diameter: 23cm x Height: 3cm
- Each glaze is completely unique and may vary from item to item.
- Stamped with an exclusive Goodhood x Liam Owen makers mark.

Reviews
There are no reviews yet.